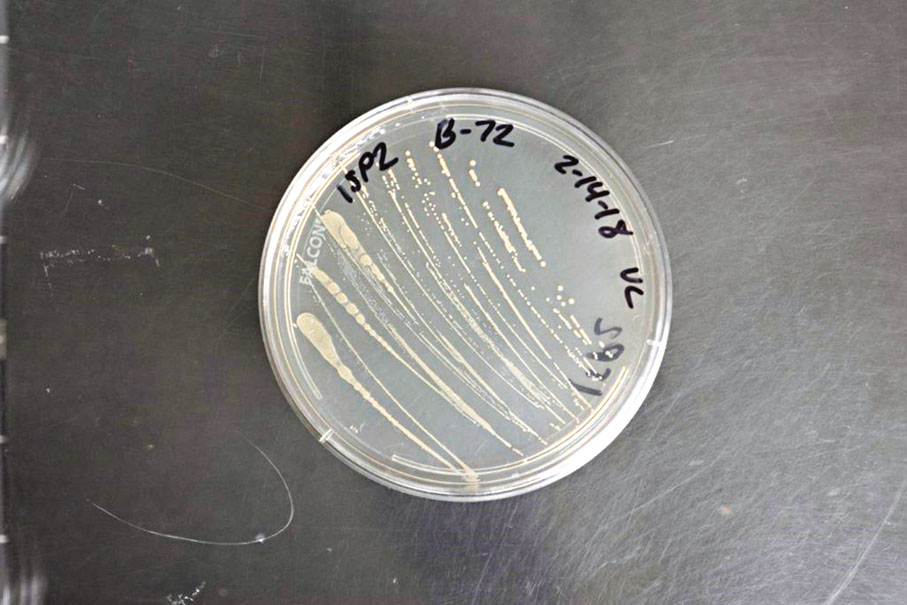
◆氧化葡糖桿菌能夠分泌出葡萄糖酸，將金屬溶解出來。 網上圖片

【科學講堂】稀土金屬難提取 細菌「工人」來幫忙

稀土金屬,是近年來全世界都在討論的熱門話題。一方面,稀土金屬的用途極廣,手提電話、風力發電螺旋槳、電池、磁鐵、處理汽車廢氣的催化轉換器等等,都用得上稀土金屬;另一方面,稀土金屬的生產方式有點兒麻煩,現時未能很方便地大量生產。一直以來我們主要利用比較化學的方法來從大自然中收集這些稀土金屬,不過近年正在開發新的方法,運用細菌幫忙進行這個工作。今次就和各位分享一下這個故事。
稀土金屬是如何開採的?
先來介紹一下何謂稀土金屬,它們是17種化學特性相近的金屬元素,因此經常出現在相同的礦石之中。它們導電的能力、磁力甚至是發出熒光的特質,讓它們十分適合各種各樣的應用。加進稀土元素,更可以增加合金的強度和硬度。
不過實際上,這些稀土金屬並不稀有,大多數稀土金屬在地殼中的含量都比銀高,當中的鑭、釹和鈰,在地殼中的數量,更是和銅與鎳不相伯仲。可惜的是稀土金屬並不密集地出現:從1公噸的岩石之中,往往只可以收集到1克的稀土金屬。而提取過程的複雜性,也限制了稀土金屬的產量。
提取過程的第一步,是先把所有金屬和其他的物料分隔。傳統的方法是加入化學性的酸把金屬溶解出來,不過研究人員已經發現,氧化葡糖桿菌(Gluconobacter oxydans)能夠分泌出葡萄糖酸,可以將金屬溶解出來;實驗更加顯示,這些由細菌生產出來的酸,比濃度相當、由化學工序製造出來的葡萄糖酸,更能從工業廢料中抽取出稀有的金屬。可惜的是,背後的原因現在還不清楚。
把金屬提取出來後,另一個重要的步驟就是將稀土元素跟其他的金屬分開(比如說鈣和鐵也可能是常見的金屬成分),這個步驟原來也可以尋求細菌的幫助。
例如,十幾年前研究就發現,扭脫甲基桿菌(Methylobacterium extorquens)一類的細菌,會分泌出一種細小的分子,和附近環境中的稀土金屬結合,以便細菌將稀土金屬吸收進體內。這些稀土金屬原來是重要的催化劑,會和適當的酵素一齊「合作」,幫助細菌把甲醇轉化為甲醛,完成一些重要的新陳代謝生化作用。就像酵母可以用來造酒,我們也可以將這些細菌視為收集稀土金屬的「工人」。
細菌和牠們的生化產品,還可能幫忙解決稀土金屬的另一個大問題:分隔。如前所述,各種稀土元素的化學特性都十分相近,因此要把它們分開,其實需要花費極大的氣力。
近年研究人員在英國橡樹芽上一種細菌之中,找到名為lanmodulin的蛋白質,與較重的稀土金屬相比,這種蛋白質對較輕的稀土金屬更加「偏愛」(「偏愛」的強度可以相差達40倍之大)。運用這種蛋白質,科學家們希望能夠開發出更有效的方法,把不同的稀土金屬分開。
小結
一直以來稀土金屬提取的方法比較麻煩,使得它們的供應變得十分緊張。希望善用細菌給予的「材料」,我們可以發展出更有效率、更環保的開採方法。
◆杜子航 教育工作者
早年學習理工科目,一直致力推動科學教育與科普工作,近年開始關注電腦發展對社會的影響。
